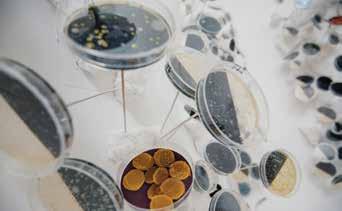

CONNECT WITH US… WWW.FAITHCONNEXION.COM MIAMI PARIS NEW YORK FAITH CONNEXION
Fund the next miracle. Please donate to the Jackson Health Foundation.


When you give to the Jackson Health Foundation, you help fund the tools our doctors and nurses use to resuscitate patients, stabilize them, heal them, and return them to the loving arms of their families. You help us continue to provide the very best that medical science has to offer. The best facilities, the best technologies, and the best people.

Your gift, of any size, helps us make miracles daily. This holiday season, we invite you to join the other donors in our community to provide the best care to all South Floridians, regardless of their ability to pay.

Call: 305 -585 -GIVE (4483) / Text: simply text “JACKSON” to 91999 / Visit: supportJHF.org
The Art Basel 2022

EDITOR & PUBLISHER
Rebeca Herrero
CREATIVE DIRECTOR
Carmen Jiménez

Equestrian Editor
Shereen Fuqua

CREATIVE CONTRIBUTOR & PHOTOGRAPHER
Gabriel Barreto, Julio Mendez, Cesar Montano, Mozes Ban, Cydney Chiamardas, Michael Goldman
EDITOR-AT-LARGE
Rosanna Perez
NYC CONTRIBUTOR
Norah Lawlor
SOCIETY EDITOR
Esther Herrero
ENTERTAINMENT EDITOR
Christian Renait
BEAUTY STYLIST
Michelle Lelia
PHOTOGRAPHY
New York and South Florida Dutch Doscher, Eglys Koelig, Jim Derks, Pedro Barboza, Malena Vazquez
CONTRIBUTORS
Miguel Sarmiento, Candida Portugues
WEBMASTER
The X Factor
ADVERTISEMENT REQUESTS: sales@artbodegamagazine.com

FOR EDITORIAL: rebeca@artbodegamagazine.com

A letter from the editor
Rebeca Herrero
Art Basel and incredible art

Art Basel is a time for celebration and what best to do but to feature the great artists that will be exhibiting during this time of the year. Becky Robbins was once married to a motivational speaker that changed lives, Tony Robbins. Her life is as interesting as the best part of the journey it entailed to develop that company, but as she mentioned to us her life is lived in cycles and she is now experiencing one of the best moments of her life, her art career. Her paintings evoke bewilderment and precise drawings that make you feel very emotional. Also artists Jordi Molla, art collector of NFT’s Crystal Rose Pierce, the magnificent Alan Faena and his celebration of 10 years of his beautiful hotel in Miami Beach with a gala that included Swizz Beats and Maria Buccellati, are some of the highlighted features on this issue. Also the Stylish Jean Shafiroff is always trying to reinvent herself, here she talks about the future of fashion and what her plans are for New York City’s fashion initiatives.
AN ARTIST TO WATCH! DISEM 305

A Miami-based artist and illustrator of Latin American and Italian descent, Disem 305 is best known for his vibrant murals featuring photorealistic portraits against pink and teal Art Deco inspired graffiti.


His work which has been referred to as both, “pretty and gritty,” can be found on walls the world over; most frequently in Miami, where the New Times - Miami's leading independent source for local news and culture, referred to his Dwyane Wade’s mural of as the “Best Public Art” of 2019. Disem’s recent works include commissions for some of the world’s largest companies, such as Red Bull and Cricket Mobile, as well as pieces made for shows at the Museum of Graffiti, Gallery 2612, and Creator Connect Gallery. His signature and highly recognizable lettering continue to grow. His brand today, expands onto apparel, housewares, and even Instagram filters. In brief, Disem’s talent constantly redefines street art. His work challenges and embraces new forms, for the world is his canvas and inspiration.
Photo Cover NYC/PB of Jean Shafiroff: Michael Paniccia
Gown by Oscar de la Renta
Photo Cover of Becky Robbins: Mozes Ban. Make Up by Iris Jimenez
Armandeus
FOLLOW US ON:
BSP Job #: JHF-21-N011A_SFBJ_FP_HolidayGiving_11x14 Client: Foundation Description: Fullpage Trim: 11 x 14" Live: 10" x 13" Bleed: 11.125" x 14.25" Color: 4c 10.07.21 9:26AM
Facebook, Twitter, Instagram
BECOMES WITH YOUR HELP, CH 3178 – A COPY OF THE OFFICIAL REGISTRATION AND FINANCIAL INFORMATION MAY BE OBTAINED FROM THE DIVISION OF CONSUMER SERVICES BY CALLING TOLL-FREE, 1-800-435-7352.REGISTRATION DOES NOT IMPLY ENDORSEMENT, APPROVAL, OR RECOMMENDATION BY THE STATE. Now Accepting Cryptocurrency Donations!
IMPOSSIBLE POSSIBLE.
from
A
Rebeca Herrero BODEG
Telephone Numbers: New York 646-761-9123 Miami 305-989-6230
E
ST Suite 505 NY NY 10029. COPYRIGHT 2021 © ART BODEGA MAGAZINE IS PUBLISHED 4 TIMES A YEAR BY ART BODEGA MAGAZINE INC ART BODEGA MAGAZINE RESERVES THE RIGHT TO DETERMINE SUITABILITY OF ALL MATERIALS SUBMITTED FOR PUBLICATION, REPRODUCTION, OR USE OF THE CONTENT IN WHOLE OR PART WITHOUT WRITTEN PERMISSION FROM THE PUBLISHER IS STRICTLY PROHIBITED BY LAW. ART BODEGA MAGAZINE ASSUMES NO RESPONSIBILITY FOR UNSOLICITED MATERIAL.
Address: 215
99th
COOL THINGS

THE SMYTHSON NOTEBOOK IS AS CHIC AS ITS HERITAGE. FOUNDED IN 1887 BY FRANK JOHN SMYTHSON, THE QUEEN HAS ENDORSED IT AND ITS FEATHERWEIGHT PAPER ENABLED SOCIETIES TO CARRY A DIARY IN THE EARLY 1900’S.










8
1 2 3 4 5 6 7 10 8 9
1. Panama Agenda with Gilt Pencil 2022, $122 2. Panama Envelope Card Case with Book, $275 3. Off the Beaten Track Travel Journal, $275 4. Pastergrain Soho 2022 Diary, Silver, $275 5. Playing Cards Nile Blue $95 6. Panama Travel and Experiences Notebook, Wisteria, $85 7. Mara Cosmetics, Red, $325 8. Mara Portobello 2022 Diary Light Steel $355 9. Panama Envelope Crossbody Bag 10. Moon Correspondence card $39
5 Land Rover unveiled the new luxury SUV, the vehicle of choice by the elite that range from royalty to politicians. The new sleek version will entice your desire to own this spectacular new version which adapts to comfort and safety as well. www.landroverusa.com

LUXURY
To not “forget the time”, the watch is wound automatically from energy generated by the wearer.

www.junghans.de
Elegant or dynamic? A moot consideration for the Meister Chronoscope. After all, this watch effortlessly combines classic charm with sporty functions. The characteristic, bowl-like dimples for the auxiliary dial are a typical feature for the Meister range. www.junghans.de
A WORLD TUCKED AWAY OF ART AND DESIGN THAT COLLIDE WITH SPLENDOR


All the products were created by top notch designers and artists
1. With exclusively curated and handpicked furniture lighting and accessories, this millionaire’s apartment is the perfect homage to the characteristic glamourous New York lifestyle. A color palette set in a neutral scale, where beiges and creams are present to create a cozy and warm appeal.


www.covethouse.eu
2. Max Bill Automatic “Watches... as timeless as can be conceived without forgetting the time.” This quote by Max Bill exemplifies his aspiration for minimalism and modernity. The characteristic, logical layout of the dial is just one example of this design icon.
www.junghans.de
8 . EV Gallery presented The stars cut open the sky, a solo exhibition of new works of layered paper by Nicole Aptekar. The stars cut open the sky opened in October.
www.evgallery.art
7 With a meticulous, modern design, the Meister fein Automatic symbolises a whole new geometry for the Meister collection. The convex form of case and sapphire crystal immediately draws the attention of the observer to the simple, yet superior design of the dial.
www.junghans.de



6. Since opening its doors in 1980, Colio Estate Wines has won over 500 awards in competitions around the globe. The Colio Estate Wines are in Southern Ontario. It was at Lake Erie North Shore, the southernmost and warmest wine appellation region of Ontario, that three Italian bricklayers named Alfredo, Enzo and Tiberio decided to fulfill their life dream of building a world-class winery.
www.coliowinery.com

11 artbodegamagazine.com
1
8
3 7 5 2 4 6
LIST
ART in LONDON

During Frieze in London, the art show Thesmophoria brought together the work of four of the most exciting young, female painters, all living and working with the UK; Ming Ying, Lily Macrae, Jessie Stevenson and Gina Kuschke. Within all four of their practices, there is an emphasis on materiality, gestural strokes, and expressionism. Whilst each artist possesses their own unique painterly language, displayed as a group a narrative emerges: an exploration and meditation on the creation of form. Soho Revue Gallery director India Rose and Purslane founder and curator Charlie Siddick brought these artists together. The show was inspired by the Ancient Greek women-only ritual in honor of the Goddess Demeter and her daughter Persephone. For more information go to www.sohorevue.com





12
THE UP-AND-COMING ARTISTS FROM ENGLAND HAVE CAPTURED OUR EYE
On top artwork by Gina Kuschke. The Hypocrites (top left) and The Drinkers (top right) by Lily Macrae (oil on canvas). Far right: Untitled by artist Ming Ying.
THE ITEM LIST

The Sophisticated Story FIVE STORY





Owner Karen Murray opens her third location in the United States at 201 Royal Poinciana in Palm Beach. The store offers the most exclusive brands as well as vintage pieces, high end accessories and exclusive items for your home.









15 14 artbodegamagazine.com
1 1 3 2 1
1. LUCE meaning “light” in Italian—offers modern American cuisine in an elegant yet inviting setting by Chef Rogelio Garcia. The dynamic menus reflect the bounty of San Francisco’s surrounding farms with regular updates according to freshness and seasonality, while their award-winning wine program offers a one-of-a-kind collection that encourages you to explore and enjoy new flavors. Located at the Intercontinental Hotel in San Francisco. InterContinental San Francisco 888 Howard Street #3011 San Francisco, CA 94103 (415) 616-6566 www.lucewinerestaurant.com. 2. DAVID RENGGLI Desire Painting (Zardo San), 2021 acrylic on wood and jute net, aluminum frame 150 x 190 cm / 59 x 74 3/4 in (DR/M 137) Courtesy the artist and Wentrup, Berlin / Photo by Matthias Kolb. 3. THE ENGINEER HYDROCARBON HOPE in support of breast cancer. www.shop.ballwatch.ch $2799
1. Savino Wine preserver at www.savinowine.com
MUSIC TO OUR EARS NAEEM KHAN & TOM VAN DER BORGHT










2. Maison d’ Etto fragrance house has created an olfactive experience consisting of ambient scenting for the NeueHouse flagship Madison Square location in New York City. The signature scent was created by Maison d’Etto’s Brianna Lipovsky and Frederic Pignault.





3. A musical companion piece to 'The Lost Words - A Spell Book' by Robert Macfarlane and Jackie Morris, with new music from an incredible collaboration between Julie Fowlis, Karine Polwart, Seckou Keita, Kris Drever, Kerry Andrew, Rachel Newton, Beth Porter, Jim Molyneux. The album CD is presented in a beautiful mixed media format. www.thelostwords.org
For this new edition of the festival of Hyères, Tom Van Der Borght presented his new collection "Time for love". The clothing becomes a living metaphor of the connection between humans. For this new season, Tom is less frontal and invites us to enter his universe while making it wearable through pieces with more ready to wear cuts. For Khan, the designer was inspired in the people from Cuba and Italy at his Spring 2022 Fashion Show at Sony Hall Fashion Week in September. Full of color and vibrancy, the designs were elegant and extremely complimentary. The Matinee Show was impactful in its array of colors and incredible uniqueness. Classical yet modern.

17 16 artbodegamagazine.com Art & Fashion
1 2 3 Phillips
Comic
Artist
Gormley
$126,000 Lift 5 (MEME) III
22,680
presents Art for Change:
Relief x Phillips
Antony
sold for
Tracey Emin, Like an old fashioned time sold for Euros
Micromoment
exhibit in Lithuania with artist Jolita Vaitkute
Naeem Khan
Tom Van Der Borght
ART BASEL Jordi Mollà in
JORDI MOLLÀ NAVIGATES THE WATERS OF ART WITH EASE


 By Rebeca Herrero
By Rebeca Herrero
The Barcelona native has been entertaining us in Hollywood since his mega movie hits “Blow” and “Bad Boys II” originally filmed in Miami decades ago, and where Molla now lives permanently since the pandemic. The house next to a waterway in Miami Beach is emblematic of his artist life, full of canvasses sprawled all around the backyard, in a nomadic and bohemian fashion the actor/painter has embraced. “I’ve been painting since I was 27 years old. I was in Paris, making a movie and to be honest I had so much time to myself, I was literally bored. This when I painted formally for the first time. I’ve continued and it’s just part of my life.” Molla has sold to 100 art collectors worldwide including Johnny Depp and the daughter of Carolina Herrera, Carolina Adriana Herrera. He has exhibited at Arco Madrid, and solo shows in Los Angeles, New York and Miami. Most recently he had 77 paintings at the Moore Building in the Miami Design District. “When I met owner Craig Robbins, we had an instant connection. He is a quiet man, like me, but we understood each other very well,” mentioned the three times Goya nominated actor whose career started in the early 90’s alongside actress Penelope Cruz in the Bigas Lunas Spanish film, “Jamon Jamon”.
The show which took place in February had his artwork for three weeks. His subjects are whimsical, a play on ideas, bet it a Zebra figure surrounded by graffiti like expressions with subliminal messages on societal criticism or an ape that looks big and dangerous with a subtle pink rose in his mouth. These are the opposite messages Molla likes to convey in his untitled pieces. He is as raw as it gets.




His new documentary with artist Domingo Zapata was filmed in Mallorca. “Zapata and I filmed for two months. It’s the story of two friends. We kept postponing it, until I insisted to my friend, it’s time to do it and we did. Titled “The Private Lives of Jordi & Domingo” will premiere at the Faena Theatre in November. The documentary was directed by Italian Giuseppe Ferlito and produced by Publikro London.
As we spoke for some time, Molla affirmed that he does roles that he love. “It’s like falling in love with a woman. It just happens. It’s unexplainable.”
19 18 artbodegamagazine.com
GALERIE HOUSE OF ART AND DESIGN





RODARTE & TOM PETTY Influencer's Guide





Kate and Laura Mulleavy, founders of the legendary fashion house Rodarte, have teamed up with Tom Petty’s daughters, Annakim Violette and Adria Petty, to release a unique limited edition capsule collection within their t-shirt and casualwear line Rodarte. The special collection celebrates the critically acclaimed re-release and in-depth look at Tom Petty’s masterpiece Wildflowers. The limited-edition, screen-printed collection includes exclusive t-shirts, sweatshirt hoodies/crewnecks and sweatpants featuring original artwork handmade by Victoria Mulleavy (Kate and Laura’s mother). The pieces are available for sale today in small quantities through www.matchesfashion.com, ShopRodarte.com and TomPetty.com.



21 20 artbodegamagazine.com Designers & Fashion
Photography by Daria Kobayashi Ritch
In Sag Harbor
ELIZABETH GILL
RAYMAN BOOZER
IKE KLIGERMAN
DWYER DERRIG
DAVID DREBIN





ARTIST DAVID DREBIN DEBUTS THE WORLD PREMIERE OF HIS “DIAMOND DUST” COLLECTION AT ART MIAMI 2021. !


He is also releasing 18 exclusive NFTs (1 of 1 each) of his Diamond Dust prints in partnership with VaynerNFT. His Diamond Dust prints sell for up to $100,000 each. www.merakia.com

22
NOTEWORTHY WHAT'S



From Wynwood to Hollywood
1. WYNWOOD WALLS

The iconic Wynwood Walls announce Miami Art Week 2021 theme is "Agents of Change" featuring 13 new mural installations by world renowned artists AIKO, Diogo “ Addfuel” Machado, Bordalo ii, David Flores, Scott Froschauer, Joe Iurato, KAI, Kayla Mahaffey, Mantra, Ernesto Maranje, Greg Mike, Farid Rueda, and for the first time, Wynwood Walls will open one wall to a local artist in an “Open Call” competition. “Since its inception, the Wynwood Walls has been a canvas created to improve the lives of others. Artists have always been agents of change, they bring joy to the world around us,” said Jessica Goldman Srebnick, CEO of Goldman Global Arts and curator of the Wynwood Walls.


2. MATTHEW BRINSTON


Former alternative rock musician-turned-artist Matthew Brinston is paying tribute to the inspiration in his life with his silkscreen paintings, “My Heroes Have Always Been Cowboys,” playing with the use of contrasting color and helping people find bits of themselves through interaction and personal synergy with the art. Created in 2017 on an Italian paper window cover, the artist reflects on childhood memories he wants to hold on to. A significant motif from growing up in Texas was a pair of red boots, which are prominent within each original silkscreen.

3. ANTHONY QUINN

CANDLES
To celebrate National Hispanic Heritage Month, Mexican American artist Anthony Quinn’s Lithograph inspired by the hymns of Pachacutec Inca Yupanqui, composed for the Situa ceremony around 1440-1450 has been made available for purchase. This Limited Edition Print entitled “The Great Spirit” from 1985 is Estate Stamped and Numbered. https://www.anthonyquinn.com/ Harcourt Rock, designed by Yoshiki for Baccarat - Yoshiki / Violaine Carrère

25 24 artbodegamagazine.com
WW MUG
1. WYNWOOD WALLS ERNESTO MARANJE
VIOLAINE CARRÈRE
2. MATTHEW BRINSTON
3. ANTHONY QUINN
WW BOOK
WW BOOK
CRYSTAL ROSE PIERCE LET THERE BE LIGHT


When you walk the cobblestone streets of Old San Juan you’ll find a historical building with a modern tech twist. The Lighthouse NFT Digital Art Space is launching immediately following Art Basel with a star-studded collection. The grand opening will feature artists with NFT collections from Christie’s and Sotheby’s displaying their works live along with pop and social media icons Alec Monopoly, Logan Paul, and Euro famous digital artist Marcel van Luit, among others.
Lighthouse has partnered with WHIM to provide a first look at the next generation digital canvases. Soon, collectors of NFT art will be able to walk away with a physical piece they can hang to display their digital works. These canvases are not yet on the public market, so this is a showroom of the future and the opportunity to be a part of the genesis collection.
“I want to shine the light from the heart of Puerto Rico. Lighthouse is a beacon for people who love creativity, crypto and community.” -Crystal Rose Pierce, Founder, SmART Gallery Puerto Rico experienced the longest blackout in US history following a devastating hurricane, so it’s appropriate the launch
event of this NFT gallery is dubbed “Let there Be Light”. The lights turn on December 8th, 2021.




The digital art gallery concept goes beyond what’s hanging on the walls. Lighthouse NFT Digital Art Space has a second level lounge and workspace, operating as a coworking space for local artists to create and learn. It also features a cafe serving artesian local coffee and farm to table fares. It is the only place in Puerto Rico where you can get a kombucha on tap.
“Traditional art galleries operate more like museums. Visitors are afraid to touch anything or relax. Collections hang for weeks or months, whereas digital art can be Let there be light 2 dynamic and show for moments. We are expanding the possibilities and evolving with the future. We want our visitors to come often and for artists to become a part of the organic culture.”
27 26 artbodegamagazine.com
Crystal Rose Pierce, Founder, SmART Gallery
Lady Macbeth NFT from the Alethea AI Revenant Collection, purchased by Brock Pierce for 31.6 ETH. This represents a new breed of AI enhanced NFTs capable of interacting with viewers.
Renderings of the Lighthouse NFT Digital Art Space in Old San Juan, Puerto Rico.
Aiden (tiger) was purchased for 12 ETH at live auction with a bid against LL Cool J and was featured in the NY Times.
Crystal Rose Pierce co-created an up-cycled dress along with fashion designer Maggy Barry. The dress is made of a recycled parachute from the Army Supply store.
CARYNA NINA

December 1st of 2021 will mark 21 years
Caryna has been designing under her own brand Caryna Nina. Known for her colorful prints, one of a kind, collectible bohemian designs that pack so easily and can be worn day into evening. It is no wonder why her best client is her repeat client and why they have been so loyal all these years. "My goal is to make women feel beautiful, confident and feminine in my luxury couture designs. Whether you are lounging at the Delano pool in Miami, at a polo match in the Hamptons, sailing in St. Tropez, or a guest at a summer wedding, you will find something special." With a degree from Pepperdine University in Art History and Fashion design degree from Parsons School of design, it is why Caryna is known for her eye to detail. Currently she is based in West Palm Beach, Florida where she does meet with clients by appointment only. Her Instagram account is: Carynanina1 and her website is www.carynanina.com Email: caryna@carynanina.com





�
2
www.solioswatches.com Palm Beach
4 3 A fresh take on sustainability powered by Solios
Photography by Cydney Chiamardas
THE LADIES OF STYLE

EACH YEAR THE GALA SUPPORTS CHARITABLE PROJECTS CONNECTED TO THE COMMUNITIES IN NEW YORK AND AUSTRIA

“THE GOLDEN AGE” SWING DINNER DANCE GALA HOSTED BY THE VIENNESE OPERA BALL



 By Elizabeth Darwen
By Elizabeth Darwen
The Viennese Opera Ball hosted their Swing Dinner Dance Gala, “The Golden Age” at a private club in Manhattan. Due to the events of the past year, the gala was scaled down from previous years with limited capacity but was a great return of the extravagant affair. The Viennese Opera Ball is a nonprofit association under Section 501(c)(3) and celebrated under the auspices of the US Austrian Chamber of Commerce. The Gala Chairs for the evening were philanthropist Jean Shafiroff, and Denise Rich. Each year, it supports charitable projects that are connected to communities in New York or Vienna. The proceeds of the Swing Dinner Dance benefited the Gabrielle’s Angel Foundation for Cancer Research.

The Gala took place with the support of City of Vienna and the Honorary Gala Chair, Governor & Mayor of Vienna The Honorable Michael Ludwig, Consul General of Austria in New York The Honorable Helene Steinhaeusl, and the Director of the Austrian Cultural Forum New York Michael Haider. Notable attendees included: President of the Viennese Opera Ball Silvia Frieser, event chair and philanthropist Jean Shafiroff, Consul General of Austria in New York The Honorable Helene Steinhaeusl, Director of the Austrian Cultural Forum New York Michael Haider, Hubert Heiss, Yoko Nakamura-Haider, Martin Shafiroff, Malan Breton, Scott Stone, Ana Stone, Eve Brookville, Sabine Riglos, Victoria Whipple, Paula Mahoney, Nelli Hantman, Imke Gerdes, Barbara Wennerholm, David Hochberg, Pamela O'Connor, Sonia Nassery Cole, Michele Herbert, Emily Mohr, Cole Rumbough, Sessa Von Richthofen, Richard Johnson. l For more information, please visit: vienneseoperaball.com
Facebook: @vienneseoperaball
Instagram: @vienneseoperaball
#vienneseoperaball #vobny

2nd row, right photo – Silvia Frieser, Hubert Heiss, Austrian Consul General Helene Steinhaeusl, Yoko Nakamura-Haider, Michael Haider.
“MURANO NIGHTS” DINNER HOSTED BY YOUNG FRIENDS OF SAVE VENICE HELPS FUND VENETIAN ART RESTORATION


 By Ann Grenier.
By Ann Grenier.
Top row, left photo –Lizzie Asher, Tai-Heng
Cheng, Alyson Cafiero
Top row, right photo –
Atmosphere
2nd row, left photo –Natalie Myer, Emily Godard, Savannah Engel, Cara Chen, Clare Ngai
2nd row, right photo –Katie Gray, Lizzie Asher, Patina Miller
3rd row – Brooklyn
Ballet
4th row, left photo –
Atmosphere
4th row, middle photo –Anthony DeWitt, Lizzie
Asher, Casey Kohlberg, Mercedes de Guardiola, Michele Levbarg-Klein
Rayden, Christina Senia, Clare Ngai
4th row, right photo –
Lizzie Asher, Casey Kohlberg
Casey Kohlberg, Lizzie Asher, and the Young Friends of Save Venice hosted Murano Nights, an intimate dinner at Casa Cipriani, the newly opened member's club and celebrity hotspot in New York City’s landmark Battery-Maritime building. The evening was to celebrate the 50th anniversary of Save Venice, which in lieu of the pandemic related postponement of its usual black tie masquerade gala, is hosting over 50 smaller dinners and parties across the world. Murano Nights included 50 of Save Venice’s fashionable younger supporters from art and fashion to film and media for a cocktail hour.

“It’s been a pretty crazy year and a half,” said host Casey Kohlberg in a sparkling Carolina Herrera cocktail dress. “But I’m honestly so excited to be able to see friends and dress up again. Save Venice Young Friends Chair Lizzie Asher, shimmering in a PatBo dress, followed the welcome remarks by sharing the myriad of restoration accomplishments Save Venice has had during its 50 years: "Save Venice has indeed been saving Venice one masterpiece at a time."
Notable guests included: Patina Miller, Serena Goh, Krystal Bick, Amir Taghi, Denise Baca, Tai Cheng, Daniel Kibblesmith, Jennifer Wright, Savannah Engel, Alyson Cafiero, Laura Day Webb, Timo Weiland, Mercedes de Guardiola, Clare Ngai, Daniel Howard, Irina Eicke-Krylova, and Maximilian Eicke.



30
Photo credit Patrick McMullan, and Rob Rich Society Allure
Photo credit BFA/Madison Voelkel
Top Photo – Silvia Frieser. 2nd row, left photo – Atmosphere
3rd row, left photo – Emily Mohr, Cole Rumbough. 3rd row, middle photo – Jean Shafiroff, Malan Breton, Silvia Frieser. 3rd row, right photo – David Hochberg, Pamela O'Connor
BARBARA M GILBERT


FROM THE ELOQUENCE OF
OF
Currently, a Vice President Banker and Wealth Manager at Valley Bank, she handles business development for commercial and private projects, throughout the Southeast coast. She thinks outside the box and goes to the end degree for a client. She is loyal as the day is long. Gilbert has been part of the very distinguished group out of Silicon Valley called Alley to the Valley. It is a venture capital group for C Level elite women, by invitation only. This year they are meeting in San Diego. Look for one in Palm Beach soon. She is proud of her accomplishments with a series 7 and 66 Licence. The Palm Beach resident is very capable of using EMoney for planning software. Gilbert also speaks publicly often, most recently on “estate planning and residency.” She is a member of the Penn Medicine Women’s Board, the Big Dog Ranch Board, the Brooke USA and The School House Children’s Museum.
Having owned her own capital campaign company, she is passionate about nonprofits. She is definitely a career woman you should watch….

32
Palm Beach
THE MAIN LINE
PHILADELPHIA TO THE CASUALNESS OF PALM BEACH, SHE IS SOMEONE TO WATCH AS SHE CRUSHES THE GLASS CEILING WITH EVERYTHING SHE DOES.
A fresh take on sustainability powered by Solios www.solioswatches.com
Photography by Cydney Chiamardas
DR.
KARYN GORDON’S DEVELOPS NEW FRAMEWORK FOR UNDERSTANDING AND DRIVING LEADERSHIP IN NEW BOOK, THE THREE CHAIRS
 By Elizabeth Darwen
By Elizabeth Darwen

World-renowned leadership & relationship expert Dr. Karyn Gordon’s new book “The Three Chairs: How Great Leaders Drive Communication, Performance, and Engagement” is making a dazzling impact on people around the globe.

The CEO and co-founder of DK Leadership has taken her riveting principles of how to develop powerful leaders at work and the home and turned them into what is destined to be a top-selling book. With the publication of the “The Three Chairs” comes the introduction on how to obtain a status that will forever change your existence for the better.
“Working with Millennials, I realized that a lot of them struggled with self-esteem and confidence,” states Dr. Gordon. “I had dug into a lot of the research about the different power of attitudes and how that impacts decision making throughout the years. I really started seeing a pattern that comes down to three attitudes that people have. When you understand what these three attitudes are, you can start making educated guesses on how people make decisions, respond to situation based on what chair they sit in.”
In the framework of the text, she explains how she came up with the three chairs as a powerful visual. Each chair represents the three different attitudes that everybody has in life. Which chair you're sitting in and which attitude you carry actually impacts your everyday behavior (communication; relationships / friendships; goal-setting; decision-making, stress-management / wellness). The three chairs are a representation of those three different attitudes and people can identify and connect too.
The groundbreaking concept is not only helping shift dynamics for Millennials. It is also creating a positive work environment across multiple platforms. “Three Chairs”
is a business book with an edge since it showcases applications to use in the office as equally as in your personal life.
“It is such an easy concept for people to understand,” the leadership & relationship expert explains. “People can quickly start seeing themselves where they sit and how it impacts their life. They can see themselves where their colleagues sit with their clients as much as with their spouses.”
The book, which includes a special forward from Shark Tank Investor Robert Herjavec, has already received rave reviews from dozens of leaders within the industry. The engaging publication is now available online and will be a featured title on Amazon.
l For more information and to purchase “The Three Chairs: How Great Leaders Drive Communication, Performance, and Engagement” please visit: dkleadership.org/ the-three-chairs-book/
ICONIC CHUCK’S VINTAGE NEW FLAGSHIP STORE BRINGS STYLISH GIFTS THIS HOLIDAY SEASON
 By Lillian Langtry
By Lillian Langtry
Chuck’s Vintage has a new store in Manhattan, and they are offering up the most stylish gifts this holiday season. Since opening on the Upper East Side this fall, fashionistas have been raving about the collection that showcases the best of the past in the present.
Chuck’s Vintage founder, Madeline Cammarata, was always about making people smile through clothing. Honoring her legacy with gifts from this timeless store will stretch the joy on with denim lovers in your life.

In 2006, Madeline started Chuck’s Vintage, which overnight became a true American original. Her abundant collection became treasured wear for celebrities and business elites from Steve Jobs to famous musicians such as Dolly Parton, Robert Plant, Morrisey and more. From the famous to just pure classic style lovers, they have all at one point crossed the threshold of Chuck’s Vintage in the California hotspot shop - where even once a world-renowned denim archivist saw fit to entrust Madeline with millions of dollars’ worth of collectible denim that she proudly sold. The new store’s showcase of vintage denim that must be seen to be believed. The blue jeans in the Upper East Side location will range from Strongholds found in the California Gold Rush mines to World War II-Era Levi’s, Lees, and Wranglers, as well as 1960’s ladies high-waisted and groovy deadstock Levi’s bells. Chuck’s will also showcase the
founder’s sampling of vintage American workwear: rugged military and work boots, buttery leather bomber jackets, and soft, perfectly worn-in vintage 70’s rock tees. Classic American Cool.
The iconic California-based Chuck’s Vintage recently brought classic style to Manhattan with a grand celebration honoring the legacy of the brand. Invited guests toasted the arrival of Chuck’s Vintage at a private party at Classic Cars of Manhattan. Notable VIP attendees gathered at Pier with live entertainment from DJ Lee Kalt and vocalist Xandra K.
Visit the flagship retail outlet to shop for time-honored clothing at 173 East 91st Street, Basement, New York, NY 10128.
l For more information, visit chucksvintage.com

34
Madeline Cammarata
CENTRO TRATTORIA & BAR BRINGS FARM-TO-FORK ITALIAN DINING EXPERIENCE TO HAMPTON BAYS




 By Ann Grenier
By Ann Grenier
Salvatore Biundo is the owner of Italian eatery Centro Trattoria & Bar, the ultimate farm-to-fork Italian restaurant in Hampton Bays. The storied road to the making of his beloved business comes from a rich background at home. His grandmother lovingly passed on the secrets of the kitchen to him.
Centro Trattoria & Bar serves dinner daily with all menu items made in house using many of the East End’s local, in season produce. Family recipes including fresh homemade pasta, individual pizzas from a wood burning oven and dishes with Mediterranean touches can be experienced in the new outdoor setting, as well as the luxurious indoor dining room that currently holds a 76-person capacity per current CDC guidelines. Menu highlights include Antipasti selec-
tions of Clams Oreganata, Grilled Octopus, Fried Goat Cheese, Mussels, Fried Sicilian Baby Artichokes, Fritto Misto, Nonna’s Meatballs, Crispy Zucchini Chips and Antipasto Classico for Two. Enjoy fresh Insalates such as Caesar Salad, Calamari Salad, Arugula & Apple Salad, and an array of mouthwatering pizzas with your choice of Margherita, Braised Short Rib, Sweet Italian Sausage, Prosciutto and Centro Rustica.
The bar boasts a craft cocktail menu with drinks infused with basil, mint and rosemary grown on site. The outdoor patio of Centro Trattoria & Bar also highlights weekly specials, as well as Aperitivo Hour on Monday, Wednesday, Thursday, and Friday from 4:00 pm to 6:00 pm. l For more information, please visit www.centrohamptons.com
NUNZI’S RESTAURANT BRINGS A MODERN TAKE TO CLASSIC ITALIAN CUISINES


 By Elizabeth Elston
By Elizabeth Elston
A family's love for good food and good vibes has created what is destined to be the hottest new restaurant in Farmingdale, New York. Inspired by a grandfather’s passion for bringing people together at a table and a grandmother’s love for food is the launch of Nunzi’s. Owner and operator Michael Napolitano along with his brother, Vincent Jr, are out to prove that the incredible dishes made in the kitchen are only to be rivaled by the fantastic hospitality of Nunzi’s. What Chefs Anthony LoCastro and Marc Wisehart have collaborated to produce, are memorable moments on a plate. With superb creations such as Pappardelle & Lamb, red wine braised lamb, tomato mushroom ragu, pancetta & shaved parmesan; the savory Heritage Pork Chop with white wine, garlic, cherry pepper jam & roasted cipollini onions; desserts like Cannoli Cream with Biscotti, and Tiramasu are perfect ways to cap off a beautiful dinner.
Not to be missed are fascinating interpretations that will satisfy the cravings of adventurous foodies such as one-of-a-kind Limoncello Chicken Wings and a boisterous menu placement of a Philly Cheesesteak Sandwich. Besides the cuisines, traditions, and respect for the good ole days,’ are incorporated into a sleek and modern layout by renowned designer Derek Axelrod. The moment guests walk in the door they are dazzled by a lively environment that is both edgy and delightful. Both Axelrod and the Napolitano’s worked in harmony to launch a soon to be Farmingdale institution. Nunzi’s seeks to enchant young and old alike by capturing a fresh, contemporary, and sleek look, with nods to the glamour and romance of classic Italian meals. Making customers happy while giving them that home feeling is the main priority of the Napolitano brothers. l For more information, please visit nunzis1274.com, and on Instagram at @nunzisfarmingdale.
EXPERIENCE VIBRANT VANCOUVER AT THE ALL-NEW VERSANTE HOTEL




 By Lillian Langtry
By Lillian Langtry
After a tumultuous year, countless Americans are eager to start exploring the world again. With the border restrictions lifted for U.S. citizens to travel to Canada since August, the time has never been better to discover (or rediscover) Greater Vancouver. The upcoming Thanksgiving and Christmas seasons – as well as Chinese New Year in February 2022 – make venturing to this renowned metropolitan destination even more attractive.
The most exciting accommodation in Greater Vancouver is Versante Hotel – the region’s newest luxury boutique hotel.
Located in the city of Richmond –20 minutes by vehicle from Downtown Vancouver –every detail at Versante has been carefully Versante Hotel boasts 100 guestrooms and suites in five bold décor themes (developed by Vancouver-based CHIL Interior Design). Wall coverings, fabric selections and furniture colors were customized to create an immersive experience within each room. Spa-like bathrooms feature the Dyson Supersonic hair dryer, large rainforest shower with heated floor, and, in most guestrooms and all suites, a freestanding soaker tub. Bath amenities are by Red Flower, a New York City brand whose acclaimed bath and beauty products are biodegradable, vegan, and cruelty-free. Versante offers a 24-hour fitness facility with Peloton bikes; a serene rooftop terrace with saltwater pool and hot tub; 5,500 square feet of function space for meetings and events; and an array of new dining concepts, including Bruno. Led by a team of industry veterans, Bruno boasts family-style share plates and destination-inspired craft cocktails, each working in tandem with one another to take guests on a culinary journey featuring the best of British Columbia. l For reservations and more information, visit: versantehotel.com.
37 artbodegamagazine.com
Nunzi’s 125 Secatogue Avenue, Farmingdale, NY 11735
Centro Trattoria & Bar
336 W. Montauk Highway, Hampton Bays, NY 11946
SHOW ME PIZZA IS SERVING UP THE HOTTEST PIES IN AUSTIN, TEXAS
 By Peter Elston
By Peter Elston
Austin, Texas is serving up the hottest new pies in town at Show Me Pizza. Known as the fun foodie capital of the world, the new Neapolitan Pizzeria is offering hand-tossed and made to order selections with topping favorites baked fresh in minutes.

Guests are in for an original fullblown immersive experience of watching their pizza cook in real time via Twitch TV at www.twitch. tv/showmepizza. From prep start of the dough to the bubbling in the oven, customers can now order a pie and watch it brown and bake before their eyes.
Order online or take a seat in the colorful garden patio to enjoy classics like Margherita and Pepperoni. There are also several creative highlights sure to appeal to residents such as the 50 First Dates pizza with
onion bechamel, mozzarella, smoked pork, roasted pineapple, thyme, and chili oil; as well as the vegetarian friendly Grazing G.O.A.T. pizza with fresh mozzarella, goat cheese, pickled cherry & banana peppers, arugula, pecorino, gaeta olives, e.v.o.o., sea salt, and basil.

Co-owner and operator Benjamin Demarchelier and partner Dimitri Voutsinas, formerly of Motorino Pizza in NYC, are demonstrating that Show Me Pizza is putting the best dishes on the table that appeal to the big Texas appetite for the best cuisine in America in the most fascinating and modern way.
l For more information, please visit www.showmepizza.com.
SHOW ME PIZZA
2809 South 1st Street, Austin, Texas 78704

GREENWICH POLO CLUB SHOWCASES CHAMPION EQUINE ATHLETES IN LEGENDARY TOURNAMENTS
 By Harry Brads
credit Greenwich Polo Club
By Harry Brads
credit Greenwich Polo Club
Nestled in the beautiful backcountry of Connecticut, the Greenwich Polo Club has hosted many of the top tournaments in Polo, including the esteemed East Coast Open.

It is also home to the acclaimed White Birch polo team, one of the most successful teams in history, having won the most high-goal polo tournaments of any team over the course of the past 25 years, including the US Open Polo Championship in 2005. Legendary teams and players including Mariano Aguerre, Facundo Pieres, Hilario Ulloa, Nacho Figueras and many others.
In 2021, the Greenwich Polo Club hosted the East Coast Bronze Cup, East Coast Silver Cup, East Coast Gold Cup, East Coast Open, Green-
CELEBRITY HOST GREG KELLY DETAILS WEIGHT LOSS JOURNEY WITH THE SKINNY CENTER
By Lillian Langtry
Talking openly about his battle with weight fluctuations, Radio/TV host Greg Kelly shares his weight loss journey with The Skinny Center, who is now a regular visitor to the exciting new medical spa, located in Harrison, New York. When asked about his remarkably healthier and leaner new body, Kelly shouts out one phrase “LAB WORK”!
HEALTH ADVOCATES NEW YORK GALA
By Cecille Langtry
Health Advocates for Older People’s New York Treasures Gala took place at a private club in Manhattan.


Co-chairs Leonard Van Lowe and Richard S. Johnson along with Executive Director, Nancy Houghton, helped host the benefit that honored the three Health Advocates’
2021 New York Treasures that include Jean Shafiroff, Evan A. Davis, and Rebecca Myers Thomas.Jean Shafiroff is a

philanthropist, humanitarian, TV host, writer, and the author of the book "Successful Philanthropy: How to Make a Life By What You Give". Often referred to as "the first lady of philanthropy" Jean serves on the boards of many charitable organizations and each year chairs upwards of eight different charity galas. Evan A. Davis has clerked for Supreme Court Justice Potter Stewart and served in the administra-
tion of New York City Mayor John Lindsay as Chief of the Law Department’s Consumer Protection Division. Rebecca Myers Thomas has served on numerous nonprofit boards including the Junior League of the City of New York, the London Service League, the Civil Support Division of the Legal Aid Society, Musica Sacra, the Gateway School, and Berkshire Choral Festival.
Visit www.hafop.org.
When talking about his journey with The Skinny Center, Kelly said “To get to the root cause and address what is really going on in your body you’ll need to schedule a visit to the Skinny Center and request “Health 365” an amazing very in-depth blood panel that reveals certain genetic markers and isolate imbalances and their underlying causes. I attribute this blood panel to my healthier and leaner body in only a short amount of time”
“I have been on so many weight loss programs in the past, but unless you know what your blood looks like under a microscope,
wich Cup, and American Cup. The club is known for its unmatched roster of legendary teams, professional players, and champion equine athletes, fondly known as polo ponies. Each Sunday match is attended by thousands of spectators flocking from New York City, Fairfield, and Westchester counties, to witness the highest caliber of polo while enjoying an afternoon with friends and family.
Greenwich Polo Club seeks to accelerate the growth of Polo in the U.S.A. and inspire the next generation of fans through an unparallel live event and lifestyle experience. l For more information, schedule, and tickets, visit: www.greenwichpoloclub.com
The Skinny Center 450 Mamaroneck Ave, Harrison, NY 10528 914-703-4811 theskinnycenter.com
there is no way for you to identify what steps you should take to protect yourself,” said Kelly. Kelly is a television personality, journalist and military veteran who brings unique insight to the day’s news. He spent nine years as a Marine Corps jet pilot, flying the Harrier jet, including missions over Iraq. In 2020, he began a prime-time nightly news and opinion show on cable TV, Greg Kelly reports. Prior to that, Kelly was the co-host of Good Day New York on Fox 5 for almost a decade. Although Kelly was exercising regularly while experimenting with various diet fads, he never reached his weight loss goals. The medical weight loss experts of The Skinny Center, zoomed in and found the reason Kelly has had so much difficulty losing weight in the past.

Kelly added “I thought I was a hopeless case before becoming a patient at the Skinny Center, I was tired, stressed out, overweight, and just given up. The Skinny Center taught me that with the

right information from Health 365, I could take charge of my weight and health, and I have never been better. Mitch Suss is really a wellness entrepreneur genius.”
“Your eyes are the windows of your soul: your hormones are the doorway to your health” – Mitch Suss, CEO and founder of the Skinny Center
l To schedule a free medical consultation and to sign up for the Health 365 lab work, call 914-703-4811.
l For more information about The Skinny Center, go to Theskinnycenter.com
39 38 artbodegamagazine.com
Photo credit Patrick McMullan
Photo
Left photo – Jean Shafiroff, Evan A. Davis Middle photo – Nancy Houghton, Martin Shafiroff, Jean Shafiroff Right photo – Rebecca Myers Thomas
Greg Kelly
Nina Christine is the creator of an elegant niche French perfume. The native New Yorker has a strong belief in the hidden positive psychological and emotional potency fragrance can bring. She served on numerous New York City charity boards over the years but is now focusing on the launch of her opulent Karma Love perfume. Having trained with Galimard in Grasse, France and the famed Parisian Olfactory School, Cinquieme Sens, Nina learned the process of scent accords, blending raw aroma materials into fragrant formations, mastering the analytical chemistry of both flavor and fragrance.

How did you start in the perfume business?
I've always had a passionate love for flowers and Perfume. Spending summers in Greece, France & Italy where fragrant flowers grow in abundance, I was inspired to capture these memories through scent...Originally the idea of creating a perfume was simply for donation purposes. I served on the Benefit Committee of numerous New York City charities, and I wanted to find a personal yet significant way to offer my contributions beyond simple monetary. The Perfume graced the silent Auction tables of my favorite charities for years. The Opera, Ballet, Italian and Scottish Cultural Causes, Princess Grace Foundation, just to name a few.
Describe the perfume…
The Perfume was inspired by the enchanting rose notes that caressed my senses while summering in the South of France. All the flowers are exclusively sourced from the Cote D'zure region so I would describe it as a gentle rose elegant feminine scent.
What compelled you to start your own brand?

I love to be creative and share beauty with the world. Bringing people joy even in the simplest way is important to me. I'm forever gifting my friends and family with floral bouquets from my garden honey from my Bee Hives. Creating something beautiful and sharing it with people has now become my passion. Growing up I was surrounded by nurturing Italian women with strong integrity, sincerity, and selflessness, a wonderful influence.
Perfumer NINA CHRISTINE
By Rebeca Herrero.
40
Photography by Michael Goldman at the Dennis Basso Boutique in Manhattan
Carolyn Murphy’s fashion collaboration with Mother’s co-founders Lela Becker and Tim Kaeding, titled Homegrown was launched at an event at a Malibu farm. The intimate luncheon with Net-a-Porter showcase the fashion line of the famous model who uses unwanted rags and Mother’s denim stock. The event raised money for the Sierra Club, $50,000 of the proceeds will be donated to the organization.



WHERE THE CELEBS ARE NOW !

GRAMMY® Award-winning artist and wellness guru DJ Khaled is bringing his CBD-infused skincare collection to the masses with his first-ever GROOMED x BLESSWELL Pop-up Tour! The music magnate’s newest platform is an immersive, ultra-luxe self-care experience that provides complimentary grooming services using the premium skin and face products of the BLESSWELL collection.

ELÁN ALLENDE, THE POP STAR

Elán Allende is an up an coming artist who has just embarked on new projects in the musical industry. Singer, musician, writer and composer, this tireless talent does not stop. He produces his own music and assembles the elements necessary to achieve his goals. He is a humble and big-hearted human being creating music for the soul. With his tropical style, he has managed to reach other cultures by collaborating with other artists, thus managing to fuse rhythms in a very interesting way. His music can be described as tropical pop ballads, with a touch of reggae and some reggaeton. In addition to being a musician, he is the father of two children who are his greatest motivation and inspiration in life. He is a great cook, he loves his home and enjoys the simple moments that the universe gives him. Although extroverted at times, he likes to socialize and share with good people and friends. As far as music is concerned, he
Acclaimed artist, contemporary American painter best known for her cityscapes of New York City, Sonya Sklaroff hosted an intimate VIP exhibition to celebrate the launch of her limited edition book Pandemic Paintings by Sonya Sklaroff at the historic Cable Building in New York’s Soho neighborhood.
Notable attendees included close friend and foreword writer Rachael Ray, her husband John Cusmano, artist, activist and politician Paperboy Prince, celebrity chef Mary Giuliani, David Kratz, actress Finnerty Steeves, SNL musicians Shawn Pelton & Elaine Caswell.



has several songs already available through all digital platforms. The Grla, Tú y Yo, Fallar, War and Suffering, are some of the songs that you can already listen to. Elán is a great creator! He takes the guitar, and in a matter of seconds he is humming a tune that is sure to end up being a great song. At the moment he is working hard to make several videos that are being filmed in various locations in Puerto Rico and he looks forward to having them ready as soon as possible for the public to enjoy. He recently had live performances in Puerto Rico and Miami. We hope you enjoy this creative process where Elán shows all his talent. This is the beginning of a great artistic career full of good music and rhythms for everyone. Remember to look for Elán Allende's music on your favorite digital platform and share with your friends to see how fun it is. Follow him on Instagram as well @elanallende and, be part of the process of seeing this star born and shine for the world.

43 42 artbodegamagazine.com
Abigail Spencer wears Monique Lhuillier at the 25th Anniversary Book Launch in Los Angeles. Photo by Jen Sosa and Kat Harris.
Model Pritika Swarup was joined by friends to celebrate Diwali and the launch of her new Indian-inspired beauty brand, PRAKTI, at the Public Hotel eatery Ava. Guests, included Nina Agdal, Brooks Nadar, Christian Juul Nielsen, and Alina Baikova.
Photo Credit: Sean Zanni
HIGHLIGHTS OF THE CITIES
Miami
WHERE TO GO!
Q&A WITH RENE LAVAN, MARGARITA LIVE


Margarita Live, a storytelling experience by Creative Director, Don Alam, and Actor, René Lavan, takes guests on an immersive sensory journey to uncover the story behind the creation of the Margarita. We spoke with Lavan to get some insight.
1. What inspired you to come up with Margarita Live?

I discovered the power of immersive theater as an actor when I was cast as one of the leading roles in the show, The Amparo Experience, in 2019. The co-creator of this project, Don Alam, had a similar experience but from the audience’s perspective and both were equally as impactful.
2. How did you learn about the history of the Margarita?
We knew there had to be more than a slogan used to advertise the Margarita cocktail, “Margarita, more than just a girl’s name,” so we looked and found stories including the legendary Rita Hayworth, famous showgirl Marjorie King and Miss Peggy Lee, to name a few.
3. What are some highlights of the show, and will there be more?
The name says it all: a live show performed by talented actors, singers, dancers, and musicians. We are preparing our larger and fully immersive Margarita Live experience, announcing tour dates early 2022.
SFLMAVEN CORP IN Fort Lauderdale
Joe Ladin is the CEO of SFLMaven Corp., an online provider of highend luxury jewelry and goods. SFLMaven has a top-rated eBay store that recently surpassed the rare level of 100,000 positive feedbacks. Joe launched SFLMaven 18 years ago and is passionate about providing his customers with beautiful high-quality products and excellent customer service. The company holds a weekly Thursday
on eBay, which features over 200 unique pieces each week. They are no reserve, which provides bidders the opportunity to decide the value of each item.


www.sflmavencorp.com






Palm Beach
Mally Skok is a Bostonbased interior designer and textile maker, originally from South Africa. Following a global upbringing, Mally and her family moved in the mid-1990s from London to America, where she launched her interior design business. Mally has since built a client base that is enamored with her creative mix of layering the new with the old and transforming homes into colorful living spaces. Her new store in Palm Beach is the place to go to.

44 artbodegamagazine.com
Store is located at Via Bice
www.shopremembar.com
“To have loved and lost is better than never having loved at all........... because you loved.”
DEATH BECOMES HER
Jennifer Graziano created jewels for OUR GRIEF
New York metro-area funeral director, Jennifer Graziano, who owns multiple funeral homes, recognized a growing trend in her industry. An attorney as well as a radio talk show host discussing prominent and pertinent age-related issues, Graziano realized a growing trend in her industry. She noted the rise in cremation and the need for beautiful, finely crafted tokens of remembrance. She created “RememBar Collection”, in 2019, soliciting the help of Ward Kelvin, former Tiffany & David Yurman designer. Graziano expanded her vision to make the pieces relevant to all people who have lost a loved one. Each 18k gold or sterling silver bar holds a portion of a loved one’s cremated remains, lock of hair or favorite perfume scent. The pieces, in addition, feature the birthstone of their loved one with the word “remember” delicately inscribed. For Graziano, it’s about turning a negative into a positive, and offering hope when it’s needed the most. www.remembarcollection.com

47 46 artbodegamagazine.com
Jewelry
Photography by Michael Goldman at the Dennis Basso Boutique in Manhattan.
By Laura Taylor Jean


49 artbodegamagazine.com
Earrings:
All photography by Michael Paniccia Hair: Henry de la Paz for Warren Tricomi Make-up : Kimara Ahnert & JP Ramirez Yellow short silk dress: Oscar de la Renta
Helen Yarmak
Long flowered gown: Victor dE Souza
PHILANTHROPIST AND STYLE ICON
ShafiroΩ
Jean Shafiroff is a well-known New Yorker who is a philanthropist, humanitarian, TV host, writer, and the author of the book "Successful Philanthropy: How to Make a Life by What You Give". Described as The First Lady of Philanthropy by Hola Magazine, Hello Magazine and many other publications, Jean works extensively as a volunteer fundraiser and leader in the philanthropic world. In 2021, Jean Shafiroff was named one of The Power Players in Philanthropy by Marquis Who's Who along with Bill and Melinda Gates, Michael Bloomberg, Oprah Winfrey, Warren Buffet and a number of others.
Jean serves on the boards of nine charitable organizations and each year chairs upwards of eight to ten different charity galas. She also hosts many other events for several different charities. Jean champions many causes including women’s rights, rights of the underserved, health care, and animal welfare. Additionally, her on-going support and passion for the fashion industry is very important.


The great Coco Chanel once stated, “Elegance is when the inside is as beautiful as the outside." As a style icon herself, Jean is inspired by these words. It is simply true to the philanthropist that when a person has a good heart and wants to find a way to give back, it is the most important thing in the world.
Jean’s captivating looks are noted at the numerous charity events she attends. While many eyes in the room take in her exquisite looks, the philanthropist is quick to note that she does not just wear a beautiful gown for the sake of putting something pretty on, but rather to show her support for the fashion industry. However, of foremost importance to Jean is the causes and charities being supported.
“It is incredibly important to support emerging designers, especially after the fashion world took such a large financial loss during the pandemic. This is something that I am passionate about and is something that Valerie Steele (Director of the Fashion Institute of Technology) told me is key to helping the industry get back on its feet,” states Jean, who serves as board member of the Couture Council of the Museum at FIT.
Black and white striped gown: Victor dE Souza Black Suede Gloves: Sermoneta Earrings: Kim Renk of Worth Avenue, Palm Beach
Red silk gown: Zang Toi
The philanthropist often wears a mix of notable designers as well as the work of young artists from across the world. Jean is now out and about supporting many different causes - and does so in style. Her love of fashion celebrates the rebirth of being able to simply dress up again in elegant attire. Like many others, the shedding of 2020 at-home attire is out and en vogue fashion is in. We are all rejoicing and taking great pride in returning to a healthy, safe and normal life again.
While her collection of high fashion gowns will one day be donated to a museum, for now she is still enjoying wearing them. Her collection includes a large number of gowns by designers Oscar de la Renta, Carolina Hererra Zang Toi, Valentino, Mary McFadden, B Michael, Malan Breton, Zac Posen and Victor de Souza.

Jean serves on nine foundation boards, with the newest position being with the South Bronx-based Casita Maria. The organization creates a welcoming community that enriches youth and families towards success through shared cultural, art and educational experiences. Jean also is a Board Member of the American Humane, Southampton Hospital Association, Mission Society of NYC, NY Women's Foundation, French Heritage Society, Couture Council of the Museum at FIT, Global Strays, and Southampton Animal Shelter Foundation Honorary Board. A Catholic, she served on the board of the Jewish Board for 28 years and now is one of their honorary trustees. She is also an ambassador for American Humane and is the national spokesperson for the organization’s “Feed the Hungry” Covid-19 program, an initiative designed to provide food for 1,000,000 shelter animals. Jean is the ambassador of the Southampton
 Cornflower blue silk dress: Oscar de la Renta
Aqua striped gown: Wes Gordon for Carolina Herrera White Gloves: Sermoneta
Cornflower blue silk dress: Oscar de la Renta
Aqua striped gown: Wes Gordon for Carolina Herrera White Gloves: Sermoneta
HER COLLECTION OF HIGH FASHION GOWNS WILL ONE DAY BE DONATED TO A MUSEUM.
JEAN IS THE PRODUCER AND HOST OF THE TELEVISION SHOW "SUCCESSFUL PHILANTHROPY" WHICH AIRS SEVERAL TIMES A WEEK THROUGH LTV STUDIOS IN EAST HAMPTON, NY.

Animal Shelter Foundation and a key donor and volunteer fundraiser for their work. Jean has been honored many times by several groups including the Stony Brook Southampton Hospital, American Heart Association, American Cancer Society, New York City Mission Society, Southampton Animal Shelter, Surgeons of Hope, Al Sharpton's National Action Network, the Ellen Hermanson Foundation, Pet Philanthropy Circle, Animal Zone International, Youth Counselling League, the NYC International Film Festival Foundation, the Jewish Board, and the Hadassah. In December 2020 Dan's Paper named her Philanthropist of the Year at their Long Island Power Women's Award Ceremony. Her list of accolades grew when the Samuel Waxman Cancer Research Foundation honored her for her work, as well as Health Advocates
A Cause So Noble, They Made a Movie About It.


for Older People for her achievements in the community at their October New York Treasures Gala.
Jean is the producer and host of the television show "Successful Philanthropy" which airs several times a week through LTV studios in East Hampton, NY, and Sun20TV in Southampton, NY. Her show also airs in New York City on Manhattan Neighborhood Network (MNN) Saturdays at 8:30 pm: Spectrum Channel 34 and 1995, Verizon/ FiOS Channel 33, Sun 20, and RCN Channel 82. She hopes to open her TV show in additional markets in 2021. On her TV program, Jean interviews an eclectic mix of leaders in the world of philanthropy as well as actors, artists, business and civic leaders, and even the former U.S. presidential candidate, Brock Pierce. Other interviews have taken place with such notables as Kerry Kennedy,
Ndaba Mandela, Rep, Caroline Maloney, Susan B. Taylor, Carol Alt, Dan Gasby, and Tony Danza.
Jean is truly one of the busiest, kindest, and most successful leaders in the field of philanthropy. Her level of commitment and dedication is highly unusual. And Jean manages to do all of her work in the most fashionable of ways.

For more information about Jean Shafiroff, please visit her social media:
Instagram: @JeanShafiroff and @JeanShafiroffAtWork
Facebook: @JeanShafiroff

Twitter: @JeanShafiroff
Helping
54
Cover Photography by Michael Paniccia
Cover gown: Oscar de la Renta Hair & Make Up for the Cover: JP Ramirez
people heal through horses since 2009. www.hhhusa.org
Red tulle gown: Malan Breton
ART BASEL NEWS




FERNANDO ALLENDE’S ART


Mexican Superstar Fernando Allende is a lot of things: singer, actor, painter, film producer and director, making him one of the first true crossover stars in the industry. Born in Mexico City, Fernando is credited as being one of the first actors of his generation to make the transition from Latin America to Hollywood, starring in notable films and TV shows such as Miami Vice, Flamingo Road and The Hitchhiker. His art is emblematic of his spirit, colorful, rich in culture thanks to his Mexican roots and as a now resident of Puerto Rico, he continues to explore the magic of the Latin inspired themes evoking a whimsical painting of figures, geometric shapes, and funny details. His art attracts a lively audience who collects abstracts and imagery with lyrical emotion.
OLGA OZERSKAYA AT CONTEXT
During Art Basel, Olga Ozerskaya will present her exhibit Rebirth. The Opening reception will take place December 2nd, from 5-8 pm at the Brickell Flatiron PH 6201 in Miami. The Gallery representing Ozerskaya is Visioner Art Gallery. She will also show at CONTEXT Art Miami during Art Basel, at B-24, VK Gallery Netherlands. “Through this body of work, I want to highlight the spiritual healing power of the 5th natural element and connect with the viewer with Mother Nature,” said Ozerskaya who currently lives in New York City but hails from Moscow, Russia.
EVENTS DURING ART BASEL

1. Tanja Stadnic is considered the #1 Porsche Artist worldwide. At The Gabriel Miami, guests will have the opportunity to paint exotic vehicles alongside Stadnic. Dec 1, 7-10 pm


2. Back to Healing (BTH) will bring museum quality art to the Gabriel Miami during a cocktail party on December 2 from 6 p.m 10 p.m. The participating artists that have exhibited at the MOMA and The Whitney, including C. Michael Norton, David Baskin, Zahra Nazari, Mariana Lagunas and more.


3. The Balfour is celebrating female street artists with a cocktail party on Wednesday, December 1 from 7 p.m. to 10 p.m. Chosen for their celebration of both art and beauty, local artists Amelia_ST, Crystal McQueen, and Florencia Clement de Grandprey will exhibit their work.
4. The Sagamore Hotel, known for its rotating experiences of museum-quality art year-round, kicks off Miami Art week 2021 on Monday, November 29th with their programming titled 'Beyond the Paint'. The hotel’s expansive lobby and entire ground floor will serve as a gallery space; more than half of which will be taken over by BitBasel - Miami’s Crypto Art Community - featuring a variety of NFTs in addition to paintings from renowned artists from around the world. The event will include Itzik Mevorach, a rising star in the Israeli art community known for his Neo Pop Art; Carlo Sampietro, an urban design artist who explores social and cultural responsibilities through his mixed media work; and French-Brazilian Pop Art couple Léo & Steph.
On Saturday, December 4th from 9 a.m. until 1 p.m
The Sagamore Hotel will host the 20th anniversary of their annual Sagamore Brunch, an iconic affair that will include art activations, a special musical performance from the South Florida Symphony,and much more.

57 artbodegamagazine.com
2 3 2 4 4 1 1
Robbins BECKY


In all her five senses ART WITH A SOUL DURING ART BASEL MIAMI 2021
 Becky Robbins, making herself at home at the Shelborne South Beach, the iconic Art Deco Miami hotel where she has her work on display during Miami Art Week, Dec. 1-5.
Robbins kicks off Miami Art Week by hosting an Art Talk at The Drawing Room, the hotel's speakeasy bar and restaurant.
Becky Robbins was styled by Caryna Nina at the Shellborne Hotel.
Caryna Nina Haute Couture Designs are available at www.carynanina.com @carynanina1 Make up by Iris at Armandeus @irisjarmandeus
Photography by Mozes Ban
Becky Robbins, making herself at home at the Shelborne South Beach, the iconic Art Deco Miami hotel where she has her work on display during Miami Art Week, Dec. 1-5.
Robbins kicks off Miami Art Week by hosting an Art Talk at The Drawing Room, the hotel's speakeasy bar and restaurant.
Becky Robbins was styled by Caryna Nina at the Shellborne Hotel.
Caryna Nina Haute Couture Designs are available at www.carynanina.com @carynanina1 Make up by Iris at Armandeus @irisjarmandeus
Photography by Mozes Ban
Becky Robbins comes across as an artist and an attractive woman who has been on a constant journey to bring wisdom and beauty in her life. Hers, as any remarkable individual would tell you, has had its difficulties; however, meeting her is just one of the highlights of our journey through the world of the arts. Her paintings: detailed, full of color, of elements, stories, combined to visualize in the idea she wants to convey. Robbins brings to the surface of her canvas, the depths of marine life. She will continue working. Robbins defines her work within the context of the Japanese word ‘Yūgen,’ meaning: “An awareness of the Universe that triggers emotional responses too deep and powerful for words.” And she is right on point for her artwork speaks for itself: Filled with life; it is compelling, the kind or art that fascinates and captivates in peculiar way. ‘Yūgen’ is also said to mean: “A profound, mysterious sense of the beauty of the universe… and the sad
beauty of human suffering.”
Though, for years her work has been exhibited through the West Coast, Robbins is now making the leap East, across the country, to bring her art to Art Basel for the first time. “It’s so exciting to show at the Shelborne Hotel. What a fantastic place! The diversity of Miami is unparalleled. So many cultures and languages. All living together, makes it so exciting,” explains Robbins during a photoshoot at the Shelborne Hotel, in Miami Beach. While posing for this issue, Robbins suggests an elegant style and adjusts to every difficult angle we ask her to model for. Be it at David’s Café, having a “cortadito,” or posing in stilettos at the elegant bar/lounge in the back of the Shelborne.
Having her paintings here denotes a substantial change in her life. “At the beginning I collected coffee table books. The process fascinated me. Creating something seemed like a magical treat. The craving to become an artist hap


61 60 artbodegamagazine.com
FINDING THE ART
pened intuitively. I was running a giant global company, all those experiences brought me to this path,” said the Colorado native, who was married to the uber famous motivational speaker, Tony Robbins. Becky was Robbins’ first wife. Tony, the man who built an empire based on motivational help, therapy, and self-help seminars. Becky lived in San Diego, while transitioning from a businessperson position with a daily routine to one of finding a new passion, so the story goes, she found her passion. “My attorney was telling me all these new things that she was doing. Piano lessons, Spanish classes, and art classes too. I wanted to do the same. I went to an art class. I learned how to do a straight line and all the technical elements needed to become an artist. That’s how I started painting,” states Robbins.
As the series became more precise, the artist began experimenting with wax, creating portraits, and storing the artwork demanded more space. So, Becky created her
own art studio and started carving her own identity as an artist. “Having traveled extensively to places like Indonesia, I can attest to this tremendous influence the ocean has had on me. I love scuba diving; on one occasion I was looking at this rock formations and the colors it showed. The waves kept pounding at them, I cried and got emotional witnessing such beauty in front of me. It is the mastery of the creation. Meeting diverse cultures, having had that experience with Tony changed my life. We were working so hard. We traveled, met different cultures. I was managing our Fiji resort. When there was a crisis, I had to hop on a plane and resolve it. - It taught me how to deal with people that were different than me….” Such experience made Becky Robbins the artist she is today.
Each piece of work takes her about six months to a year to finish. Her art underlines such creative drawings, the pieces come just so close to perfection. Whether she
draws a jaguar with a heart behind him, a lady with an Octopus head, her genius lies in the soul of her paintings. She always envisions an element of surprise which connects and runs through the entire piece. “The painting is not done until you sign it. That’s when I arrive at the conclusion that I’ve completed an art piece,” concludes Becky.
When it comes to her personal life, Robbins’s story is fascinating. She met Tony Robbins during a seminar, before he was famous. “We met; we fell in love… I was struck by his presence. He is 6’7” and I am 5’4”. You can imagine... I thought, he could become president of this country. That’s how much confidence he inspired,” explained the San Diego resident.
By the time Becky met Tony, she was 34 and already had three children. The couple moved to San Diego. Becky became the engine behind the man. She helped the business grow and had full faith in him. “But my life
is cyclical. I live in cycles. At some point, the marriage could go no further. I had to find my own path in life,” explains Becky.
Becky did the “Walk on Fire” that Oprah Winfrey so famously walked on while filming for Tony’s T.V. show.
“You have to understand the metaphysical power of it. It is possible to get burned and I did a couple of times; but it is a transforming experience. I’m also a meditator and it continues to be a source of gentle strength for me,” says the former Mrs. Robbins.


Meeting Becky Robbins does have a calming effect on you. A kind tranquility that is peaceful. A living emotional art piece you want to have in your living area. A sense that all is beautiful and serene. In her work one can feel that she pours all her senses into it. She goes full force with an unusual focus and intensity. That is what makes her feel alive, how she takes on her artwork. It is what drives her.
The Shelborne was originally built in 1940 and designed by famed Art Deco architects Igor Polevitsky and Thomas Triplett Russel. It was embellished in the 1950s by Neo-baroque design master Morris Lapidus.
63 62 artbodegamagazine.com
The hotel houses an iconic Art Deco pool, David’s Cafe (For authentic Cuban coffee) and Sweet Beach, with cuisine by



64
James Beard Winner Michelle Bernstein.
The Woman Behind Miami’s Art World
Art, and the will to help others run deep through Elizabeth Reyes’ veins, the driving force behind the Blink Group. Her father, Andrés, a former Navy Seal, National Geographic’s photographer, is also a renown independent filmmaker, lecturer, painter, and illustrator. Her uncle, Emilio Sánchez, winner of multiple prestigious art awards through the world and designer of the Forever Stamp, was a painter, philanthropist, a master portraitist of urban scenes in general, New York
City in particular. Sanchez’s legendary U.S Postal Stamp’s work is a forever ajar window to the world and its art.

COVID-19 has made the last couple of years a make-or-break period for all sorts of businesses, a true resilience test. The Pandemic hit the galleries hard, particularly the artists. Through it all, true to her heritage and company’s mission, Elizabeth has been there for her artists and clients alike.
Today, she is pleased to announce that Blink Group will, once again, be taking part in Art Basel’s Art Miami and Context Art in its 2021 physical and virtual versions.
Miami’s Art Basel from Opening Night on Tuesday, November 30th, through Sunday, December the 5th.


Location:
The event will take place at One Herald Plaza @ NE 14th Street, Downtown Miami On Biscayne Bay between the Venetian & MacArthur Causeways. You can find Blink Group Exhibits in The Art Miami Pavilion, at Textile Art Booth A11. Tickets available online only.

Alan
Faena



Architecture of Being

The author writes on eight thematic pillars: Creation, Vision, Weakness, Silence, Path, Present, Love and Architecture. These chapters explore the inspired source from which all creativity emanates, from the personal battles to the deliberate decisions that ultimately define Faena’s vision and infuse his imaginative vision.

67 66 artbodegamagazine.com
BILLY MONSALVE DUFFO Evanescent ANDY PRUNA No Fishing
CARLA D'AMATO The Golden Crown
Colonitzada nº36 Around The World
Available at Amazon.com & Faena.com
Gala




FAENA









69 artbodegamagazine.com
Clockwise from Top Left: Son of music producer Swizz Beats, Nasir Dean entertained the crowd. Christina Estrada, Maria Buccellati, Kinga Lambert and Monica Kalpakian. Adriana Cisneros and Alan Faena with a guest. Chloe Lazard. Wolf of Wall Street, Jordan Belfort and his wife. Omar and Maria Buccellati. Alan Faena, his son and right hand woman Nicole.
CARLTON FINE ARTS
CHARLES SAFFATI
CHARLES SAFFATI REFLECTS ON 50+ YEARS OF CARLTON FINE ARTS

MULTIGENERATIONAL FAMILY ART GALLERY
Carlton Fine Arts on Madison Avenue is a family business. “My father was in the business, and I quickly took over when I became of age,” says Charles Saffati, the current proprietor. Saffati considered himself “of age” at 14, when he began showing up to work at the gallery after school. Now his son Morris is in the business with him. “He's 40 years old now and he also came to me after school,” Saffati adds.

PICASSO, WARHOL, CHAGALL, HARRING, MIRÓ & MATISSE
Started in 1969, Carlton Fine Arts specializes in modern masters and pop art. “From the beginning we started with masters: Picasso, Chagall, Miró, Giacometti, Matisse,” says Saffati. As time progressed, he brought in newer artists, like Andy Warhol and Keith Haring in the 1980s. “At the time, those were the new upcoming type of artists. I mean, I used to buy Keith Haring works for $1,000.”
GOOD INSTINCTS
In addition to dealing with timeless bluechip artists, Saffati continues to add new talent as the art world evolves. Now CFA handles contemporary artists like Kaws, who is already a household name, Ron Agam, and Mr. Brainwash, a graffiti artist with a Bansky-type style. The artists were featured in the 2010 documentary Exit Through the Gift Shop, directed by Banksy.
MR. BRAINWASH
Saffati’s instincts have paid off. “We carried Keith Haring when nobody even knew who he was. Even Andy Warhol, we carried him when there was very little recognition of his work.” The gallery tries out new artists that they feel are setting new trends going forward. “I feel like that right now with Mr. Brainwash,” says Saffati. “We started on the ground level with him, but I really see how it's been exploding in the last two years.” What makes Mr. Brainwash special, he feels, is his use of iconic images like Einstein, Char-
lie Chaplin, Mickey Mouse, and Keith Haring. “It's graffiti. He uses spray cans and stencils to spray the way graffiti artists used to do on the wall, but he does it on a canvas or on paper, and then he splashes the paint in the back, all over the piece.”
9/11 20TH ANNIVERSARY MEMORIAL
An unexpectedly moving opportunity arrived this year when the 9/11 Museum asked Carlton Fine Arts to host an unveiling of a piece by artist Charles Fazzino that was later installed at the museum. Yankee legend Bernie Williams and the fire and police commissioners attended the gallery event.
ART BASEL MIAMI BEACH
Carlton Fine Arts showed at the Hamptons Fine Art Fair in the summer and will be showing at Art Basel Miami in December. They will be featuring one of their newer talents, Chinese multimedia artist Linjie Deng. Deng has made a splash recently with some anti-racial art related to the uptick in attacks on the
EXHIBITIONS
Asian community in America. “He was mugged, he experienced it, and it was picked up by all the various TV stations,” says Saffati. “And me being Jewish and Hispanic, I’ve experienced racial hate, so that's one of the reasons I picked him up, because I felt for him, and he had a very good message in his heart.” He added that Deng is also a part of the LGBTQ community, and the gallery featured his work along with other queer artists and allies in a Pride Month exhibit titled “Queer Art 1950s-2021.”
PHILANTHROPY
Saffati is very involved with Bikur Holim, a charity that serves people with illnesses, the poor and the elderly. He’s also active in his synagogue’s Sephardic Center, which is similar to a JCH or YMCA, with locations in both New York and New Jersey. The gallery has also held exhibitions for the Make-AWish Foundation and similar organizations. carltonfa.com
71 70 artbodegamagazine.com
EXPERIENCE
MODERN AXE THROWING EXPERIENCE IN MANHATTAN LIVE AXE: EAT, DRINK THROW
 By Bennett Marcus
By Bennett Marcus
THE DRAW
Part of the experience is in doing something unique. “You get excited. You see people being tense, and then half an hour later, screaming and yelling and rooting for their friends, getting very competitive,” Segal explains. As it’s a fairly new activity, there are not many people who are really good at it, so everyone is competing at the same level, and you don’t feel intimidated. “Unlike, say, bowling, where there are people who have been playing since they were young.” says Segal.
INNER VIKING
Throwing an axe is a vigorous activity, you’re moving your body, using energy. The cage captains offer encouragement and tips on stance and accuracy. Opened during the pandemic, Live Axe faced some delays due to Covid-related restrictions, but has now been steadily operating since December, with social-distancing and other protocols in place. Axe-throwing is not required, and in fact, a lot of well-dressed folks come by after dinner for drinks. The bar recommends that people wear flat shoes, but they do have some on-hand for those in heels or sandals who decide spur of the moment to embrace their inner Viking.
POPULAR WITH ALL AGES
The proprietors have been amazed at the variety of people Live Axe has attracted. A few months ago, a woman held a 35th birthday party there with over 45 guests. Not long after, the birthday girl’s mother celebrated her 76th at the venue with a bunch of female friends, all of similar age. “They had so much fun, these mature ladies,” Segal says. “And they said next time they’re bringing their husbands.”
CORPORATE EVENTS
Segal has been surprised at how popular the place has proven for corporate events. “ People are branching out, and it’s fun for everybody,” he says. With different sections on different levels, parties can have their own space, or even their own floor.
RAGE ROOM & GLOBAL EXPANSION
FIRST LADY OF FLORIDA

CAROLE CRIST
By Rodney Sparrow
CREATOR: ZAC SEGAL
Live Axe, a bar and lounge featuring axe throwing, brings a sophisticated, New York City-level experience to this activity that has become popular across the U.S. Manhattan’s first axe-throwing venue. Live Axe offers delicious food, including vegetarian and gluten-free options, an elevated cocktail menu in a Viking-themed bar, and chic, Instagram-friendly industrial design in its 10,000 square-foot Soho space. And no worries, it’s perfectly safe to hang out there – the axe throwing is relegated to cages and guided by highly trained “Axperts” called Cage Captains.
INSTAGRAM BACKDROPS
“We elevated the experience, it’s not just a barn or warehouse,” says founder Zac Segal. “I don't think there's any other axe throwing place in the world that does it the way we do, with everythingthe music, the food, the drinks, the design - together.”
Throughout the stylish space graphic walls designed by different artists in a variety of materials provide perfect Instagram backdrops. “The vibe is like going to a fancy lounge in Manhattan,” says Segal
In the planning stages is a “rage room,” in which you are invited to break things. It could be plates or glassware, or monitors , computer, or anything that comes to mind . (We can all relate to that!) You choose your weapon, perhaps a sledgehammer, baseball bat, or, yes, an axe, and smash the object. Loud music may be your accompaniment, getting you even more keyed up - or more concisely, more gleefully vengeful.
“It definitely matches axe throwing, so I'm not going in different directions. It's adding one more way to be active, to be social.” Explains Zac. In the future, he’s planning to open additional Live Axe locations, in big cities both in the U.S. and abroad. liveaxe.com
Starring: Kelsey Grammer, Julia Stiles & Nicolas Cage
CHAMPION FOR THOSE IN NEED
After an esteemed career in private business and public life, it’s now all about how and whom she can help. While many know Carole Crist as the former First Lady of Florida, she is equally known in philanthropic circles as a champion for those in need. Her personal and professional experiences in public and private life have honed her understanding of the impoverished and the underserved, giving her unique perspective on the “who” and “how” one can make a difference.
the technology sphere. Developing disruptive technologies not only shakes things up, but also brings positive 21st-century solutions to the problems facing society today and generates outsized returns to investors. To paraphrase JFK, impact investing is the proverbial “rising tide that lifts all boats.”
CAPITAL WITH A CONSCIENCE
If impact investing is the tide, then Carole Crist is a wavemaker. Carole is the Founder of CLC Global Advisors, a firm that works alongside select clients and family offices whose shared objective is to build businesses that can have significant impact around the world. Coining the phrase “capital with a conscience,” Carole and fellow business leaders have made waves in various industries. “Investors have myriad choices for how to allocate human and financial capital. Why not deploy it with a purpose into ventures that have a positive impact on people’s lives? It is classic doing well by doing good,” she says.
WOMEN IN LEADERSHIP
FISHER ISLAND
Crist is a native New Yorker, but now calls Fisher Island, Florida “home”. After earning a degree from Georgetown University Business School, she went on to take the reins of her family’s 100-year-old Halloween company for 25 years and built a global private jet business, among her various corporate ventures.
IMPACT INVESTING
This path has led Carole into the world of “impact investing.” People invest money to advance a social agenda and expand opportunity for those in need, typically in
Carole’s foremost passion is the advancement of women in business. She emphasizes a shocking statistic: only 2% of venture capital dollars go to companies founded by women. This is a tremendous disparity she hopes to rectify by both raising awareness and actively engaging in female startups. It is worth noting research shows that businesses with women founders tend to have a higher rate of success. “I see elevating women as my highest calling,” she says. Crist believes we must do all we can to support women in business and fuel their success.
“By helping women break into the technology field and the venture capital realm, I know that our world will be more equitable, inclusive and successful for generations to come.” carolecrist.com
73 72 artbodegamagazine.com
PHILANTHROPIST
“Carole at home” “Doing well by doing good.”
Zac Segal
FIVE-STAR BEAUTY TREATMENT

DR. MARIE HAYAG
BEST IN BEAUTY
Dr. Marie Hayag’s concierge dermatology practice, Fifth Avenue Aesthetics, located on Manhattan’s Upper East side, caters to her nationwide patient base. Board certified in dermatology, Dr. Hayag creates a unique incredible experience for her clientele. Beyond evaluating the patient’s whole face and analyzing the different angles, contours, and facial proportions, most importantly she simply listens.
DESIRED OUTCOME
“During a cosmetic consultation I listen to a patient’s desired outcome, concerns, fears and what is important to them. I then incorporate those factors, educate the patient about the procedures, and lay out a curated plan to meet these desires based upon their facial anatomy. I also stress the importance of continuing cosmetic maintenance treatments and proper skincare regimens to enhance their skin’s appearance both for the near term and the future.”
THE SPA AT FIFTH AVENUE
Considering Dr. Hayag’s emphasis on skincare maintenance through both cosmetic treatments and daily routine, she founded The Spa at Fifth Avenue located within her Manhattan practice. Under her medical directorship, top celebrity estheticians deliver amazing treatments in a serene relaxing environment. The Spa at Fifth Avenue offers not only phenomenal facials, but the licensed estheticians are certified to deliver various skin enhancing treatments including microneedling, Biologique remodeling facial and LED Therapy. These devices can stimulate collagen production, sooth post procedure irritation and swelling or give an immediate red-carpet glow and lift for that special event.
BEAUTY
Appointments for Dr. Hayag’s services has never been stronger “The last several months I have had a constant demand for my cosmetic treatments. I see this trend across all age demographics, from my younger patient that wants preventative treatments to address fine lines before they occur to patients who desire a thread lift dubbed the “ non-surgical facelift.” Dr. Hayag still schedules time in her week to consult with new patients largely referred to Fifth Avenue Aesthetics from existing clients.
Dr Hayag recently announced the grand opening of her Palm Beach, Florida satellite office to service the needs of her patient base. Appointments are booking for January 2022. mariehayagmd.com

Avenue Aesthetics 185 Banyan Boulevard
875 Fifth Avenue West Palm Beach, FL 33401 mariehayagmd.com 212.722.2055
74
Marie V. Hayag, M.D. Fifth Avenue Palm Beach Fifth
It’s a Triple Tie for Kat Fuqua’s Grand Remo, DreamGirl & Consent, all earn Grand Champion of major championships this year. “She’s an outlier,” says Tom O’Mara, President of US Equestrian. And outside the norm, Kat Fuqua is all that. Our Art Bodega Spring/Summer thirteen year old Cover Girl Kat reportedly continued her champion equestrian quest to major Grand Championships for three of her top sport horses, and more. She is an eight time USEF Horse of the Year recipient in her eight year career with too long to note all her champion stats. A full time eighth grader at Holy Innocents Episcopal School of Atlanta, Kat is a quiet humble girl outside the ring. But fierce and determined inside. Her first double AA hunter circuit pony trainer & Big “R” judge Mindy Darst in 2014 gave her a t-shirt boldly stating Refuse to Lose, just weeks before her battle with cancer. In 2018 Jimmy Torano the South Floridian bred Big “R” Judge, Trainer and Grand Prix International Jumper took over Kat’s training with six horses and ponies at the time. “Right off the bat with her, she took off like gangbusters. Things just keep going along. The kid’s a super talent!” he says.
She ended the 2021 Winter Equestrian Festival (WEF) season at Palm Beach Equestrian Center with two circuit championships in April, besting the twelve week circuit in their respective 3’6” divisions. Grand Remo, a ten year old Dutch warmblood, claimed large Junior Hunter younger circuit title; as Consent, a nine year old Westphalian claimed his division title in the small Junior Hunter youngers. Not to be left behind, her stunning thirteen year old Dutch warmblood dressage DreamGirl won FEI Prix St. Georges for USDF Silver Medal most adults only aspire for.

After a nice return and rest on Fuqua’s beautiful acclaimed Collecting Gaits Farm outside Atlanta, she returned to compete with the very best at the USEF Junior Hunter finals in Devon, PA in July. Consent took Reserve Champion, while Grand Remo finished Cham-




Atlanta
KAT FUQUA HITS IT OUT OF THE PARK!
By Emily F. Templeton
pion of their respective divisions & Remo then named Overall JR Grand Champion Hunter amongst over 200 sport horses. Her equitation horse Itteville finished 6th of 132 competitors in the Gladstone Cup. Heading north to a cool summer in Traverse City, Michigan the Fuqua Dream Team were first to ever compete in Jumpers and Dressage. Her newly arrived Dutch warmblood Gargarian from Holland carried her to Team Fourth and Individual Tenth in 1.20 meters or 4 feet high jumps at the invitational FEI North American Youth Championships, while DreamGirl scored three bronze medals in FEI JR Dressage. Not happy with the outcome, ten days later outside Chicago DreamGirl & Kat were led by Olympian Michelle Gibson trainer and Olympian groom Rafa Hernandez at the national Dressage Festival of Champions taking FEI JR Dressage Overall Trophy, hitting the cover off the ball and making the big leagues!
Onward and upward pushing all the limits, this summer turned out to be the most significant career changing season for the young competitor. The chameleon qualified and ranked number one, for not one but three hunter fall indoor championships, Pennsylvania National, Washington International and National Horse Shows. And no surprise, Kat placed Champion at each one; Consent was
Champion and Grand Champion at Harrisburg, Grand Remo was Champion at Washington in Tryon. Most amazingly the two hunters won for the second straight year Champion of their divisions, and Grand Remo was named Grand Champion JR younger in the final inning. But don’t forget DreamGirl who scored big, winning her Regional FEI PSG Championship in October in Atlanta. To top it all off the US Hunter Jumper Association named Kat the Southeast World Champion Hunter Rider Of The Year.
FIVE TOOL PLAYER, Kat polishes her equestrian discipline skills from three time USEF Pony Hunter Champion, to Champion World Hunter Rider, to high flying Jumpers to International Dressage and her ever elusive major championship goal of Big Equitation. Art Bodega will be proud to see where it all goes in the years ahead, and maybe five rings one day. Only time will tell for her mantra for the sky is her limit! Train hard, Win easy. But back in school for the rest of the school year in her maroon colored plaid uniform, Kat humbly states, “I couldn’t do it without my parents, trainers, and Lydia, our farm manager, all the people who help me manage my very loved horses. I just love hugging my horses and taking care of them at home. It’s our special time together.”
77 76 artbodegamagazine.com
Grand Slammer toWorld Champion:
COLLEEN SULLIVAN

Known for her beautiful design transformations, Sullivan helps homeowners and investors attain their South Florida dreams by elevating outdated spaces into chic, functional coastal spaces fit for resort style living.

Dedicated to bringing you unparalleled results, Sullivan can custom design or stage your home to heighten in person or online appeal to help sell your home for more money in less time and for investment rental or vacation properties. She facilitates the process of getting you top rental income, and a quick return on your investment. Her stylish logo defines her, and her great taste for the best and know how it’s what defines her as one of the top interior designers in Palm Beach.
For more information contact Sullivan at: Tel. 760-809-9636 and her email is palmbcinteriordesign@gmail.com
( Instagram is: #palmbeachgroove)

78
The Interior Designer in Palm Beach
MAKE UP ARTIST IRIS JIMENEZ instagram: @irisjarmandeus tel. 786-788-2989 Miami Madrid
Photography by Cydney Chiamardas

Join Us For Our Annual Benefitting the Jackson Health Foundation Miracle Fund Event Chairs Ana and Cecil Milton Soho Studios Downtown Miami 7 P.M. For more information, visit www.GoldenAngelsGala.com SATURDAY, JANUARY 29, 2022

By Rebeca Herrero
By Rebeca Herrero





















































 By Elizabeth Darwen
By Elizabeth Darwen




 By Ann Grenier.
By Ann Grenier.







 By Elizabeth Darwen
By Elizabeth Darwen


 By Lillian Langtry
By Lillian Langtry






 By Ann Grenier
By Ann Grenier


 By Elizabeth Elston
By Elizabeth Elston




 By Lillian Langtry
By Lillian Langtry
 By Peter Elston
By Peter Elston



 By Harry Brads
credit Greenwich Polo Club
By Harry Brads
credit Greenwich Polo Club




































 Cornflower blue silk dress: Oscar de la Renta
Aqua striped gown: Wes Gordon for Carolina Herrera White Gloves: Sermoneta
Cornflower blue silk dress: Oscar de la Renta
Aqua striped gown: Wes Gordon for Carolina Herrera White Gloves: Sermoneta



















 Becky Robbins, making herself at home at the Shelborne South Beach, the iconic Art Deco Miami hotel where she has her work on display during Miami Art Week, Dec. 1-5.
Robbins kicks off Miami Art Week by hosting an Art Talk at The Drawing Room, the hotel's speakeasy bar and restaurant.
Becky Robbins was styled by Caryna Nina at the Shellborne Hotel.
Caryna Nina Haute Couture Designs are available at www.carynanina.com @carynanina1 Make up by Iris at Armandeus @irisjarmandeus
Photography by Mozes Ban
Becky Robbins, making herself at home at the Shelborne South Beach, the iconic Art Deco Miami hotel where she has her work on display during Miami Art Week, Dec. 1-5.
Robbins kicks off Miami Art Week by hosting an Art Talk at The Drawing Room, the hotel's speakeasy bar and restaurant.
Becky Robbins was styled by Caryna Nina at the Shellborne Hotel.
Caryna Nina Haute Couture Designs are available at www.carynanina.com @carynanina1 Make up by Iris at Armandeus @irisjarmandeus
Photography by Mozes Ban































 By Bennett Marcus
By Bennett Marcus











